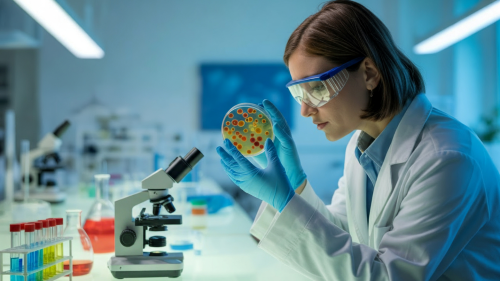

Dubai Healthcare Consultancy offers cost-effective, prompt, authentic, and high-quality Health Authority Registration, Dataflow Verification, License Exam Booking and License Exam Preparation services to doctors, nurses, and allied healthcare professionals seeking to advance their careers in Dubai, Saudi Arabia, Oman, Bahrain and Qatar.
*Monday - Friday, 9am to 5pm
click on the options to send an instant Whatsapp message at +971 54 319 9048